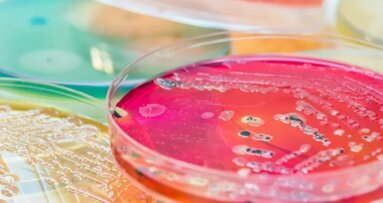
„Сякаш бактериите пътуват на стоп заедно с гъбичките“ – изследване представя способността на организмите да се движат по повърхността на зъбите

РОЧЕСТЪР, Ню Йорк, САЩ: В първото проучване, което пряко свързва пренаталните хормони на стреса с ерупцията на млечните зъби, изследователи от САЩ съобщават, че сред майките от социално-икономически неблагоприятни среди, тези, с високи пренатални нива на хормона на стреса кортизол, са склонни да имат деца, чиито млечни зъби пробиват по-рано. Резултатите от проучването сочат, че ранното поникване на зъбите може да бъде ранен индикатор за ускорено биологично стареене, свързано със социално-икономическа неравнопоставеност и пренатален стрес.
„Тук показваме, че по-високите нива на хормони, свързани със стреса, особено на кортизол, при майката в края на бременността са свързани с по-ранното пробиване на млечните зъби при бебето“, заяви в прессъобщение водещият автор д-р Ying Meng , доцент в Училището по медицински сестрински грижи на Университета в Рочестър.
Д-р Менг и нейните колеги анализираха данни от кохорта от 142 социално-икономически обезкуражени майки в САЩ, които са били бременни между 2017 и 2022 г. и са се записали в Медицинския център на Университета в Рочестър. Всички бебета са родени доносени. В края на второто и третото тримесечие на бременността всяка жена е дала проба от слюнка, от която са измерени нивата на кортизол, естрадиол, прогестерон, тестостерон, трийодтиронин и тироксин. След това изследователите са оценили времето и броя на пробилите млечни зъби на 2, 4, 6, 12, 18 и 24 месеца.
Прореждането на зъбите показа голяма вариабилност през първите 24 месеца. На 6 и 12 месеца съответно 15,2% от децата имаха между един и шест проредени зъба, а 97,5% имаха между един и 12. Всички деца имаха между три и 20 прорезили зъба на 18-месечна възраст, а на 24 месеца само 25% имаха цялото млечно съзъбие. При 2,7% от децата се наблюдаваше внезапен скок в ерупцията между 12 и 18 месеца, докато при останалите се наблюдаваше по-продължително, макар и нередовно, поникване. Ранната поява на зъби не беше надежден показател за броя им при по-късни посещения.
По време на бременността 36,6% от жените са имали диагноза депресия или тревожност. Изследователите обаче са установили, че тази диагноза не е била свързана с нивата на хормоните им или с броя на появилите се зъби на децата им в нито един момент.
Важно е да се отбележи, че по-високите нива на кортизол в слюнката в края на бременността са свързани с по-голям брой прорезили зъби на 6-месечна възраст. Бебетата на майките с най-високи нива на кортизол са имали средно с четири прорезили зъба повече на тази възраст в сравнение с бебетата на майките с най-ниски нива на кортизол.
„Високите нива на кортизол при майката в края на бременността могат да променят растежа на плода и минералния метаболизъм, включително регулирането на нивата на калций и витамин D – и двата от които са от съществено значение за минерализацията на костите и зъбите. Известно е също, че кортизолът влияе върху активността на така наречените остеобласти и остеокласти – клетки, отговорни за изграждането, оформянето и преобразуването на костите“, каза д-р Менг. Тя продължи: „Тези резултати са още едно доказателство, че пренаталният стрес може да ускори биологичното стареене при децата. Преждевременното прореждане на зъбите може да служи като ранен предупредителен знак за нарушено развитие на устната кухина и общо здраве на бебето, свързано със социално-икономическа лишаване и пренатален стрес.“
Авторите също така съобщават за връзка между нивата на половите хормони естрадиол и тестостерон при майките и по-голям брой прорезили зъби на 12-месечна възраст, въпреки че тази връзка изглежда по-слаба. Подобно слаби, но статистически значими положителни връзки са открити между нивата на прогестерон и тестостерон при майките и броя на прорезилите зъби на 24-месечна възраст, както и между нивата на трийодтиронин при майките и броя на прорезилите зъби на 18- и 24-месечна възраст.
Естрадиолът, прогестеронът и тестостеронът играят ключова роля в развитието на плода и теглото при раждане. Авторите предполагат, че това може да обясни как по-високите нива на тези хормони могат да повлияят на момента на пробив на зъбите.
„Все още имаме важни въпроси, които се нуждаят от отговор, например кои майчини хормони или последващи пътища на развитие обуславят промяната във времето на поява на зъбите, каква е точната връзка между ускорения пробив на зъбите и биологичното стареене и развитие, и какво означава това ускорение за общото здраве на детето“, заключи д-р Менг.
Проучването, озаглавено „Пренатални хормони в слюнката на майката и моментът на прореждане на зъбите в ранното детство: проспективно проучване на кохорта от новородени“, бе публикувано онлайн на 18 ноември 2025 г. в списанието Frontiers in Oral Health.
Теми:
Етикети:
Всеизвестно е, че първите 1000 дни след зачеването оказват значително въздействие ...
Френска компания представи иновативна електрическа четка за зъби, която ...
Рекламите на продукти за избелване в социалните мрежи показват известни личности, ...
Навиците, свързани с начина на живот, като пушене, консумация на алкохол или ...
В днешно време видеоселфитата, заснети със смартфон, са популярен начин за ...
САO ПАУЛО, Бразилия: Заместителите на захарта се промотират като по-здравословната ...
Филаделфия, САЩ: Изследователски екип от Университета на Пенсилвания е установил, че ...
Немски изследователи откриват, че вегетарианците имат по-добър пародонтален статус ...
Британски зъболекар разработил приложение, което насърчава четкането на зъбите. ...
Любителите на виното могат сериозно да увредят зъбите си, ако не вземат предпазни ...
Уебинар на живо
пн. 6 юли 2026
7:00 (EET) Sofia
Уебинар на живо
ср. 8 юли 2026
3:00 (EET) Sofia
Dr. Mark Donaldson BSP, ACPR, PHARMD, FASHP, FACHE
Уебинар на живо
ср. 8 юли 2026
3:00 (EET) Sofia
Уебинар на живо
ср. 8 юли 2026
8:00 (EET) Sofia
Prof. Gianluca Gambarini MD, DDS
Уебинар на живо
чт. 9 юли 2026
5:00 (EET) Sofia
Dr. Jae Seon Kim DDS, MSD, FACP, CDT
Уебинар на живо
чт. 9 юли 2026
8:00 (EET) Sofia
Dr. Armando Lopes, Dr. Carlos Moura Guedes
Уебинар на живо
пт. 10 юли 2026
3:00 (EET) Sofia



 Австрия / Österreich
Австрия / Österreich
 Босна и Херцеговина / Босна и Херцеговина
Босна и Херцеговина / Босна и Херцеговина
 България / България
България / България
 Хърватия / Hrvatska
Хърватия / Hrvatska
 Чехия & Словакия / Česká republika & Slovensko
Чехия & Словакия / Česká republika & Slovensko
 Франция / France
Франция / France
 Германия / Deutschland
Германия / Deutschland
 Гърция / ΕΛΛΑΔΑ
Гърция / ΕΛΛΑΔΑ
 Унгария / Hungary
Унгария / Hungary
 Италия / Italia
Италия / Italia
 Нидерландия / Nederland
Нидерландия / Nederland
 Скандинавия / Nordic
Скандинавия / Nordic
 Полша / Polska
Полша / Polska
 Португалия / Portugal
Португалия / Portugal
 Румъния & Молдова / România & Moldova
Румъния & Молдова / România & Moldova
 Словения / Slovenija
Словения / Slovenija
 Сърбия & Черна гора / Србија и Црна Гора
Сърбия & Черна гора / Србија и Црна Гора
 Испания / España
Испания / España
 Щвейцария / Schweiz
Щвейцария / Schweiz
 Турция / Türkiye
Турция / Türkiye
 Великобритания и Ирландия / UK & Ireland
Великобритания и Ирландия / UK & Ireland
 Международни / International
Международни / International
 Бразилия / Brasil
Бразилия / Brasil
 Канада / Canada
Канада / Canada
 Латинска Америка / Latinoamérica
Латинска Америка / Latinoamérica
 САЩ / USA
САЩ / USA
 Китай / 中国
Китай / 中国
 Индия / भारत गणराज्य
Индия / भारत गणराज्य
 Пакистан / Pākistān
Пакистан / Pākistān
 Виетнам / Việt Nam
Виетнам / Việt Nam
 АСЕАН / ASEAN
АСЕАН / ASEAN
 Израел / מְדִינַת יִשְׂרָאֵל
Израел / מְדִינַת יִשְׂרָאֵל
 Алжир, Мароко и Тунис / الجزائر والمغرب وتونس
Алжир, Мароко и Тунис / الجزائر والمغرب وتونس
 Близкият Изток / Middle East
Близкият Изток / Middle East

To post a reply please login or register